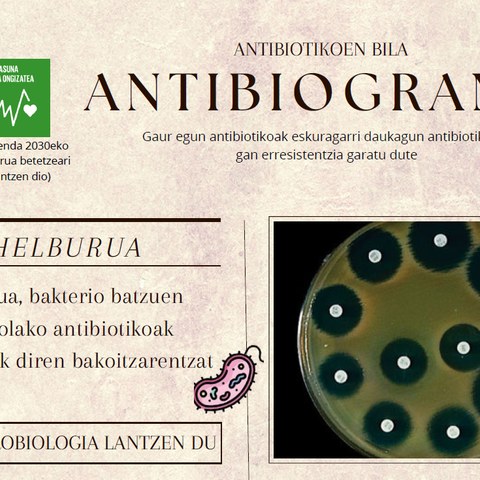

Aurkeztutako proiektuak
Lyme gaisotasuna saihesten laguntzen duen aplikazioa

- Osasuna
- Biologia / Geologia
- ingurumena / Ekologia
Errenazimenduko muraleen zaharberritzea Adimen Artifizialarekin

- Humanitateak
- Ingeniaritza teknologia
Zilarrezko Ispilua
- Ingeniaritza teknologia
Zigarrokinen Eta Botiken Eragina Hazien Erneketan. Erna
- Biologia / Geologia
Zer Egingo Zenuke Atzamarrik Gabe?
- Ingeniaritza teknologia
Uraren Eutrofizazioa
- Biologia / Geologia
Ur Suziria 2
- Ingeniaritza teknologia
Ur Suziria 1
- Ingeniaritza teknologia
The Fire Fighters
- Ingeniaritza teknologia
Stop Throwing App
- ingurumena / Ekologia
Rov Urpekaria
- Ingeniaritza teknologia
Purpurina Biodegradagarria
- ingurumena / Ekologia
Pultsometroa
- Ingeniaritza teknologia
Psikomotronik
- Energia
Ponpak Egiten Dituen Makina
- Ingeniaritza teknologia
Ph-A, Koloreekin Jolasean?
- Biologia / Geologia
Ortu Adimentsua 5
- Ingeniaritza teknologia
Nola Eraiki Zuten Stonehenge?
- Ingeniaritza teknologia
Memoria Jokoa
- Ingeniaritza teknologia
Makuluak
- Osasuna
Magia Edo Zientzia?
- Biologia / Geologia
Landareen Ureztatze Mekanizatua
- Ingeniaritza teknologia
Kultibo Hidroponikoa
- ingurumena / Ekologia
Joystick Bidez Kontrolatutako Drona
- Ingeniaritza teknologia
Itsuentzako Makila Adimenduna
- Ingeniaritza teknologia
Itsuentzako Makila
- Ingeniaritza teknologia
Hunter Girls
- Humanitateak
Herschelen Esperimentua: Infragorrien Detekzioa Arduino Bidez
- Ingeniaritza teknologia
Gailu Elektronikoak Kargatzeko Zapatilak 3
- Ingeniaritza teknologia
Future Street
- Energia
Ez Nazazu Presionatu!
- Osasuna
Euri Ura Birziklatzen
- Ingeniaritza teknologia
Etxerako Eguzki-Plaka
- Energia
Etxe Domotikoa
- Ingeniaritza teknologia
Etiketek Engainatzen Gaituzte?
- Osasuna
Espazioa Esploratzeko Ibilgailua
- Ingeniaritza teknologia
Enigma: Mezuak Kodifikatzen Dituen Makina
- Ingeniaritza teknologia
Energia Undimotriza
- Ingeniaritza teknologia
Edari Energetikoak
- Osasuna
Dentsitateak Ikertzeko
- Biologia / Geologia
Codenebu: Espazioan Mezu Seguruak Bidaltzeko Sistema
- Ingeniaritza teknologia
Checkosmetics
- Osasuna
C Bitamina, Molekula Organikoaren Adibide Bat
- Biologia / Geologia
Bioplastikoak, Biodegradagarriak?
- ingurumena / Ekologia
Biogelak
- ingurumena / Ekologia
Biodiesela
- Energia
Bioauka
- Biologia / Geologia
Bakterioak Non?
- Osasuna
Aspiraezer2000
- Ingeniaritza teknologia
Arkatz Hegalaria
- Ingeniaritza teknologia
Aluminium Recycle: A Sustainable Resource For The Future
- ingurumena / Ekologia
Ogian Agertzen Den Lizunaren Hazkunde-Patroiaren Azterketa Baldintza Desberdinetan

- Osasuna
- Biologia / Geologia
- ingurumena / Ekologia
Klimaren detektibeak 4
- Ingeniaritza teknologia
RAINEFIT
- Energia
SEAMILL
- Energia
FANBYUS
- Energia
PLAYNERGY
- Energia
Klimaren detektibeak 2
- Ingeniaritza teknologia
Klimaren detektibeak 1
- Ingeniaritza teknologia
EKORAIN ETXEA
- Ingeniaritza teknologia
ETXEBERDE: alderdi jasangarriaz diseinatutako etxea
- Ingeniaritza teknologia
GOIKOETXE
- Ingeniaritza teknologia
ECO-LOVE ETXEA
- Ingeniaritza teknologia
Argi ultramorearen bidez bakterioak hil
- Biologia / Geologia
Sunny Night
- Ingeniaritza teknologia
Ekonomia zirkularra erabiliz moluskoen oskolekin egindako material berria
- ingurumena / Ekologia
Moon Camp edo nola joan ilargira bizitzera
- Ingeniaritza teknologia
Etxea eraiki material jasangarriekin
- Ingeniaritza teknologia
Etxetxo jasangarria
- Ingeniaritza teknologia
Auto elektrikoa
- Ingeniaritza teknologia
Tenplo Maia ekinozioan
- Ingeniaritza teknologia
NEWTONN'T
- Ingeniaritza teknologia
CigEnergy
- ingurumena / Ekologia
Muñeca De Reanimación Cardiopulmonar
- Ingeniaritza teknologia
Underheating
- Energia
Humidity Power
- Energia
Ureztatzeko sistema baten monitorizaziorako aplikazio mugikorra
- Ingeniaritza teknologia
Newtonian and Non-Newtonian fluid, what's the difference?
- Ingeniaritza teknologia
Zientziaren parkea (Argiaren bila)
- Ingeniaritza teknologia
Etxebizitza Ekoefizientea 2
- Ingeniaritza teknologia
Etxebizitza Ekoefizientea 1
- Ingeniaritza teknologia
Etxea
- Ingeniaritza teknologia
Supermerkatua
- Ingeniaritza teknologia
Etorkizuneko kotxea
- Ingeniaritza teknologia
Ur suziriak
- Ingeniaritza teknologia
Konbersrar zapata ekologikoa
- ingurumena / Ekologia
Katxarroa
- Ingeniaritza teknologia
Japan Arcade
- Ingeniaritza teknologia
Ur araztegia eraikitzen
- ingurumena / Ekologia
Zubiak eraikitzen
- Ingeniaritza teknologia
Hidrolisia erabiliz, PET plastikoa degradatzen
- ingurumena / Ekologia
Bisuteria eraldatzen
- ingurumena / Ekologia
Garraitron
- Ingeniaritza teknologia
Cerebrum XIX
- ingurumena / Ekologia
EskolAPPioak
- Ingeniaritza teknologia
DEAN
- Energia
The Energy Power
- Energia
Kutsaduraren bioindikatzaileak
- Biologia / Geologia
(Cu)ncrete
- Energia
Institutuan dauden bakterio kopuruak eta desifekzio metodoen ikerketa
- Biologia / Geologia
Eskuko bakterioen azterketa
- Biologia / Geologia
Eskuko bakterioetan desinfektatzaileen eragina
- Biologia / Geologia
Plastiko organikoak sortzea
- Biologia / Geologia
Leitzaran ibaiaren ur kalitatea
- Biologia / Geologia

 Biologia / Geologia
Biologia / Geologia
 Energia
Energia
 Humanitateak
Humanitateak
 Ingeniaritza teknologia
Ingeniaritza teknologia
 ingurumena / Ekologia
ingurumena / Ekologia
 Osasuna
Osasuna